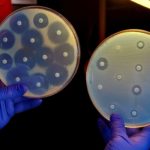

Home Search
clinical research - search results
If you're not happy with the results, please do another search
Novartis All Set To Trial Its Next-Gen Antimicrobial Drug In Africa
Medicines for Malaria Venture (MMV), an organization aimed at finding methods for reducing the burden of malaria in disease-endemic countries, and the Swiss drugmaker,...
Computer Simulation Suggests Superior Class Of Drug To Treat TB
Tuberculosis infects millions of people every year and requires at least 6 months of treatment with multiple drugs. Granulomas are complex lung lesions that...
Call For BIRAC Innovation Fellows UIC – Anna University | Fellowship of Rs. 50,000/-...
Biotechnology Industrial Research Assistance Council established University Innovation Cluster in Anna University to professionally support students in the ideation stage to establish their Biotech...
Biotecnika Times – Newsletter 21.08.2017
Research Fellowship to be hiked to 70,000 Rs Per Month | 180% Hike
In a surprise announcement at the 67th foundation day of IIT Kharagpur,...
‘A Modem For The Mind’: Start-up To Develop Brain-Modem That Restores Sight, Hearing, And...
Move past augmented reality and HoLolens, bud- a bunch of rookies fuelled by ramen and energy bars are inventing the future of mind reading.
Paradromics,...
Biotecnika Times – Newsletter 18.08.2017
CDSA Hiring for Field Monitor Position | Benefits of Rs. 15 lakhs Insurance Cover + Remuneration
CDSA invites applications for the below position, for the...
Biotecnika Times – Newsletter 17.08.2017
Govt Job : 36 RA & 32 SRF Post Vacant @ Directorate of Plant Protection, Quarantine & Storage
Notification for engagement of Research Associates and...
Scientists Create AGS Human Stem Cell-Based Model To Aid Study Of The Inflammatory Disorder
AGS is an inflammatory neurological disorder. First described in 1984, AGS typically involves early-onset inflammation affecting the brain, immune system and skin. Its severity...
Breakthrough In Cancer Detection : New Technique To Diagnose 100 Days Earlier Than Traditional...
Chief scientific officer of oncology at Natera, Jimmy Lin, is pioneering early detection of cancer DNA in the bloodstream. The best way to maximize...
New Antibiotic Susceptibility Test Detects Resistance In Less Than 30 Minutes
Antibiotic resistance is a global threat to human health. The emergence and spread of antibiotic-resistant bacteria are aggravated by incorrect prescription and use of...
Immunotherapy Approach Found To Stall Diabetes Type I Successfully
In a landmark study, researchers compared immunotherapy based treatment for type 1 diabetes with placebo and showed that the novel immune treatment can stop...
Kite Pharma Submits IND To The FDA For Trial Initiation Of Anti-BCMA CAR-T Therapy...
The LA-based leading cell therapy company, Kite Pharma, said it has submitted to the FDA an Investigational New Drug (IND) application to launch a...
Diabetes Cure Near-At-Hand : Scientists Develop First-Ever Stem Cell Implants
Diabetes is a chronic condition affecting more than 422 million people worldwide, according to an estimate by the WHO. There are two forms of...
CRISPR Facilitated Skin Grafts May Help Manage Diabetes
In a cutting-edge work by scientists at the University of Chicago Medical Center, genetically modified skin grafts was demonstrated to protect mice from developing...
RCB Young Investigator Awards 2017 | Get Stipend of Rs.75,000/- p.m.
RCB Young Investigator Awards 2017
The Regional Centre for Biotechnology (RCB) is an institution of national importance established by the Govt. of India through the...